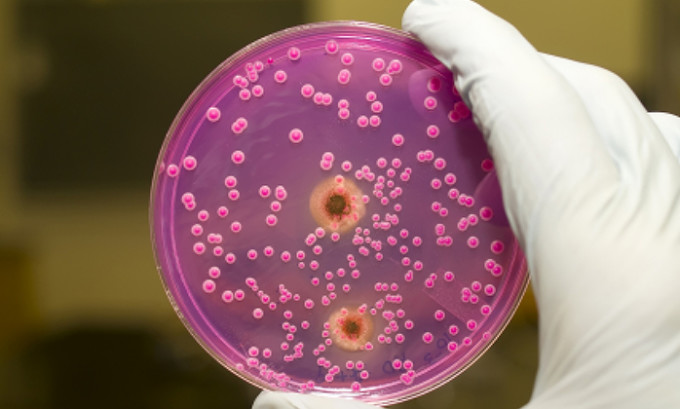

Туберкулез – это микробная, специфическая и хронически протекающая инфекция.
Важно
Вопреки распространенному мнению, что туберкулез поражает только легкие, он опасен для всех тканей тела, за исключением волос и ногтей. Но легочные формы инфекции наиболее распространены, поэтому для диагностики этой формы применяют посевы мокроты.
Но это не единственная методика определения болезни. Нередко туберкулез протекает скрыто, его принимают за ОРВИ, бронхиты, пневмонии и другие проблемы здоровья, важно вовремя его определить, так как лечение длительное, сложное и многоэтапное, подавить бактерии непросто.
Методы выявления туберкулеза: определение микобактерий
Чтобы определить наличие патогенных бактерий в организме больного, можно использовать несколько методов исследования. К ним относят микроскопию мокроты (метод Циля-Нильсена), люминисцентное исследование, посев мокроты (или бактериоскопия) и метод ПЦР-реакции.
Все эти тесты обнаруживают наличие микобактерий туберкулеза в образцах мокроты, собранной по всем правилам и немедленно доставленной в лабораторию.
Важно
Чтобы результаты были достоверными, берется не одна, а три пробы мокроты, из каждой берется необходимый объем материала для исследования.
Результаты считают положительными, если хотя бы в одной из трех проб обнаруживаются микобактерии туберкулеза – кислотоустойчивые микробы. Для всех этих исследований берут мокроту, которую получают при откашливании или за счет отсасывания из бронхов или бронхоскопии.
Врачи подчеркивают важность посева мокроты как одного из ключевых методов диагностики туберкулеза. Этот тест позволяет не только подтвердить наличие инфекции, но и определить чувствительность микобактерий к антибиотикам, что критически важно для выбора эффективного лечения. Специалисты отмечают, что правильная подготовка пациента и соблюдение всех этапов забора образца играют решающую роль в точности результатов. Кроме того, врачи акцентируют внимание на необходимости своевременного проведения исследования, особенно у людей с высоким риском заболевания. Раннее выявление туберкулеза способствует снижению заболеваемости и смертности, что делает посев мокроты незаменимым инструментом в борьбе с этой опасной инфекцией.

Бактериоскопия в диагностике
Данный метод на сегодняшний день, наряду со всеми другими, относится к ведущему методу диагностики туберкулеза. Он помогает визуально определить микобактерии, и сделать выводы о том – есть он в образцах или нет. Этот метод, хотя он простой и примитивный, не уступает многим другим более сложным и дорогим методикам в точности. Исследование проводится после получения образца мокроты при откашливании:
- Мазок окрашивается специальными красителями;
- Просматриваются на предметном стекле под микроскопом, используя иммерсионную систему.
- В приготовленном мазке микобактерии, устойчивые к кислоте, приобретают красное окрашивание.
- Результаты определяются на протяжении часа, но иногда для подготовки и исследования нужно около суток.
Важно
Методика доступная и простая, экономичная и может применяться в любой клинике. Однако, нет строгой специфичности исследования, она выявляет любые микобактерии, даже те, что не приводят к воспалению легких и поражениям.
Люминисцентный метод обнаружения
Для этого исследования мокрота готовится так же, как для обычной микроскопии, но используется особый микроскоп, который выявляет свечение микобактерий желтым цветом, когда весь фон при этом окрашен в синий цвет. При помощи этой методики определяется еще и количество возбудителей, и по нему можно говорить о тяжести состояния и длительности туберкулеза.
Посев мокроты на туберкулез — это важный диагностический метод, который вызывает много обсуждений среди пациентов и медицинских работников. Многие пациенты отмечают, что процедура может быть неприятной, но необходимой для точного определения наличия инфекции. Врачи подчеркивают, что этот анализ позволяет не только выявить туберкулез, но и определить его чувствительность к антибиотикам, что критически важно для выбора правильного лечения.
Некоторые люди выражают беспокойство по поводу времени ожидания результатов, которое может занять несколько недель. Однако специалисты уверяют, что это время оправдано, так как точность диагностики напрямую влияет на эффективность лечения. В целом, большинство пациентов понимают важность посева мокроты и готовы пройти эту процедуру ради своего здоровья.

ПЦР-исследование на микобактерии
Это современный высокоинформативный метод выявления бактерий. Он определяет ДНК микобактерий, которая специфична для каждого типа возбудителей. В лаборатории воспроизводят копирование участка ДНК бактерий, что позволяет определить его затем за счет определенных реактивов и методов идентификации. Метод точно выявляет туберкулез.
Бактериологическое исследование: посевы мокроты на туберкулез
Это один из стандартов исследования на туберкулез, он проводится всем пациентам после забора материала. Посевы проводят на специальные питательные среды, и достаточно даже небольшого количества живых туберкулезных палочек для их идентификации. Рост бактерий длительный, посевы готовят долго, могут быть сроки от 3 до 12 недель.
Важно
Колонии туберкулезных бактерий имеют специфичный вид, по которому их можно распознать. При помощи данной методики можно определить еще и бактериовыделение (когда пациент особенно опасен).
Оценка результатов проводится в баллах. Нормативом будет отрицательный посев, не обнаруживающий роста бактерий. Положительные результаты трактуют как:
- 1 балл – скудная картина туберкулезной инфекции;
- 2 балла – умеренное выделение бактерий;
- 3 балла – обильное бактериовыделение.
При результате 3 балла пациент опасен для окружающих, у него туберкулез имеет активное течение, микробы вредят его здоровью.
Важно
Также в результате исследования определяют еще и чувствительность посеянных бактерий к антибиотикам и химиотерапевтическим препаратами. После выращивания колоний на питательных средах проводят тест на препараты и по его результатам вносят коррективы в лечение.

Как собирать и сдавать посев мокроты на туберкулез
Мокрота выделяется легкими при различных патологиях, в том числе и при туберкулезе. Она может иметь различный характер – слизистая, кровянистая, гнойная. Отделение мокроты происходит при кашле, поэтому можно собрать ее как при откашливании, так и за счет аспирации из бронхов. Чтобы результаты были максимально достоверными, важна правильная методика забора материала:
- Мокрота сдается утром после сна, строго натощак;
- Перед сдачей анализа не нужно чистить зубы;
- Важно заранее прополоскать полость рта теплой водой;
- Мокроту стимулируют к отделению за счет серии из трех глубоких вдохов;
- За счет кашлевых толчков откашливается комочек мокроты, который собирается в стерильную емкость, которую сразу же закрывают и доставляют в лабораторию. При сборе мокроты краев емкости не касаются, это может привести к искаженным результатам.
Особенностями сбора именно на туберкулез являются некоторые дополнительные пункты в сборе. Так, процедуру проводят в отдельном помещении, где активно вентилируются комнаты, либо есть открытое окно, в отсутствии посторонних или членов семьи, чтобы не распространять бактерии. Затем комната, где был больной и собирал мокроту, тщательно проветривается.
Материал собирают трижды, каждое утро, используя новый контейнер. Если мокрота плохо откашливается, проводят ингаляцию с физраствором для стимуляции и откашливания.
Плюсы посевов мокроты на туберкулез
Хотя сегодня туберкулез можно выявлять различными методами – флюорография, пробы Манту и Диаскинтест, для подтверждения инфекции необходимо обнаружение бактерий. Учитывая, что данные посева оценивают в совокупности с ПЦР, бактерископией, это дает максимально точный результат. Помимо этого, определяется еще и наличие бактериовыделения – то есть заразной стадии инфекции. Помимо прочего, посевы дают возможности определить необходимые лекарства, к которым чувствительны бактерии, что помогает в лечении туберкулеза. При закрытой форме туберкулеза мокрота не будет обнаруживать наличие бактерий.
Парецкая Алена, врач, медицинский обозреватель
Вопрос-ответ
Как проводится посев мокроты на туберкулез?
Посев мокроты на туберкулез проводится путем сбора образца мокроты пациента, который затем помещается на специальную питательную среду. Образец инкубируется при определенной температуре, что позволяет выявить наличие бактерий Mycobacterium tuberculosis. Процесс может занять от нескольких недель до нескольких месяцев в зависимости от метода диагностики.
Какова роль посева мокроты в диагностике туберкулеза?
Посев мокроты является одним из основных методов диагностики туберкулеза, так как позволяет не только подтвердить наличие инфекции, но и определить чувствительность бактерий к антибиотикам. Это важно для выбора правильной терапии и предотвращения развития устойчивости к лекарствам.
Как подготовиться к сдаче анализа на посев мокроты?
Перед сдачей анализа на посев мокроты рекомендуется избегать приема пищи за 2-3 часа до процедуры. Также важно сообщить врачу о принимаемых лекарствах, так как некоторые из них могут повлиять на результаты анализа. Врач может порекомендовать специальные методы сбора мокроты для повышения точности результатов.
Советы
СОВЕТ №1
Перед сдачей мокроты на анализ убедитесь, что вы понимаете, как правильно собрать образец. Используйте стерильный контейнер и следуйте инструкциям врача, чтобы избежать загрязнения образца.
СОВЕТ №2
Собирайте мокроту утром, после того как проснетесь, так как в это время в дыхательных путях скапливается большее количество секрета. Это поможет получить более точные результаты анализа.
СОВЕТ №3
Если вы принимаете какие-либо лекарства или проходите лечение, обязательно сообщите об этом врачу. Некоторые препараты могут повлиять на результаты посева, и врач сможет дать рекомендации по времени сдачи анализа.
СОВЕТ №4
Не забывайте о важности последующего наблюдения. После получения результатов анализа обязательно обсудите их с врачом, чтобы определить дальнейшие шаги и при необходимости начать лечение.